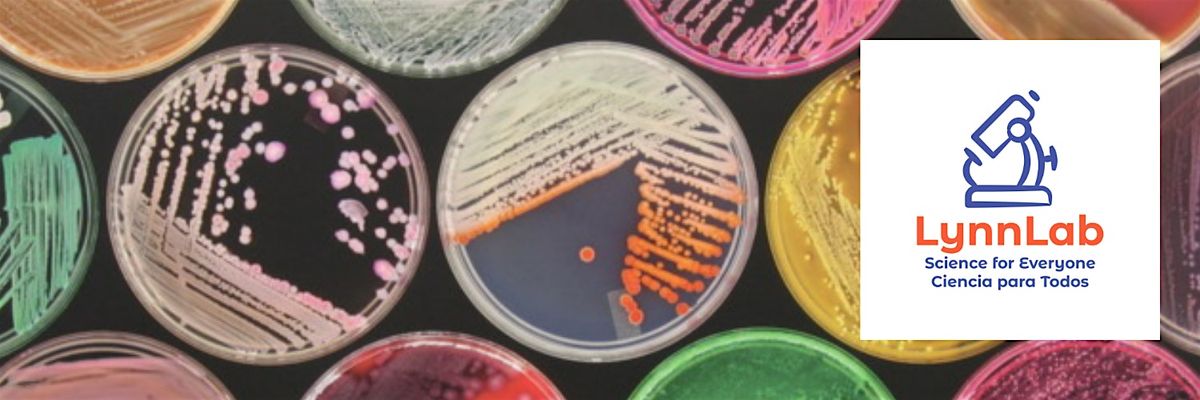

Agar Art Workshop for Adults
Schedule
Wed May 20 2026 at 06:00 pm to 08:00 pm
UTC-04:00Location
The Brickyard Collaborative | Lynn, MA
About this Event
This event is free to Lynn residents, please email [email protected] for the discount code with street address included in the subjectline!!
Petri Dish Picasso: Create Living Art with Microbes
What happens when science meets creativity? You get agar art—a unique way to “paint” with living microbes!
In this fun, hands-on two-hour workshop from LynnLab at the Brickyard Collaborative, you’ll learn how scientists use sterile technique and special tools to create designs on nutrient agar plates using harmless microorganisms. Instead of paint, you’ll use microbes to draw patterns, shapes, or even tiny masterpieces that will grow into colorful living art over the next few days.
We’ll start with a short introduction to microbiology and lab techniques, then you’ll head to the lab bench to create your own design. No science background is needed, just curiosity and a sense of fun.
During the workshop you will:
- Learn a few real microbiology lab techniques
- “Paint” with microbes on agar plates
- Create your own living work of art
- Discover the surprising beauty of the microbial world
Your plate will stay at the lab to incubate, and within a few days your microbial masterpiece will appear.
All materials and safety equipment are provided. Come try something different, get a little creative, and see science in a whole new way.
Where is it happening?
The Brickyard Collaborative, 760 Western Ave, Lynn, United StatesEvent Location & Nearby Stays:
USD 28.52




















